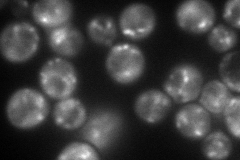

View description
Component of the exomer complex, which also contains Csh6p, Bch1p, Bch2p, and Bud7p and is involved in export of selected proteins, such as chitin synthase Chs3p, from the Golgi to the plasma membrane
Localization:
Intensity:
Fold change:
Significance:
-
C’ GFP library in SD

punctate76.25 -
N' NOP1pr-GFP in SD
cytosol,punctate122.785 -
N' TEF2pr-mCherry in SD

cytosol,punctate186.725 -
N' NATIVEpr-GFP in SD

punctate49.6894 -
N' TEF2pr-VC and Cyto-VN in SD

punctate52.9174 -
C’ GFP library in SD+DTT

punctate98.31.28No -
C’ GFP library in SD+H2O2

punctate90.341.18No -
C’ GFP library in Starvation Media

punctate91.071.19No -
C’ GFP library on the background of Pup2-DaMP

punctate -
C’ GFP library on the background of CCT mutant

punctate91.07581.19418No
